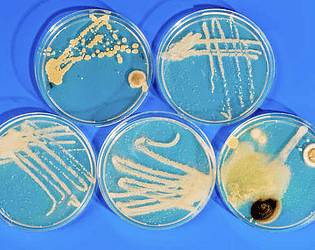

Majesty Funky Tiger Highsaturn
37
Posts
8
Topics
772
Followers
494
Following
A member registered Jul 04, 2016 · View creator page →
Creator of
playtest & calibrate your Windows system
Autojunkio SFX synthesizer delirium
for world class arcade video aficitionados
Recent community posts
Memory Cards community · Created a new topic Sprite Kid's Playset Lite ( Yo-Yo LP ) 🍕🌶️🍗🍿🦠 AVAILABLE NOW
itch.io Community » General » Release Announcements · Created a new topic Autojunkio 🌺🌐 Surf Shack Forum Page
ALOHA!
WELCOME TO AUTOJUNKIO!
~
KICK BACK
RELAX
AND TALK ABOUT ANYTHING ONLINE!
~
GET THE LATEST UPDATES FRESH FROM THE SOURCE!
[ https://autojunkio.itch.io/memory-cards ] 🕹️🐯
SPECIAL STATS!
SALE PROMOTIONS!
RELEASE DATES!
EXCLUSIVE PREVIEWS!
A Palace for Fools comments · Replied to Majesty Funky Tiger Highsaturn in A Palace for Fools comments